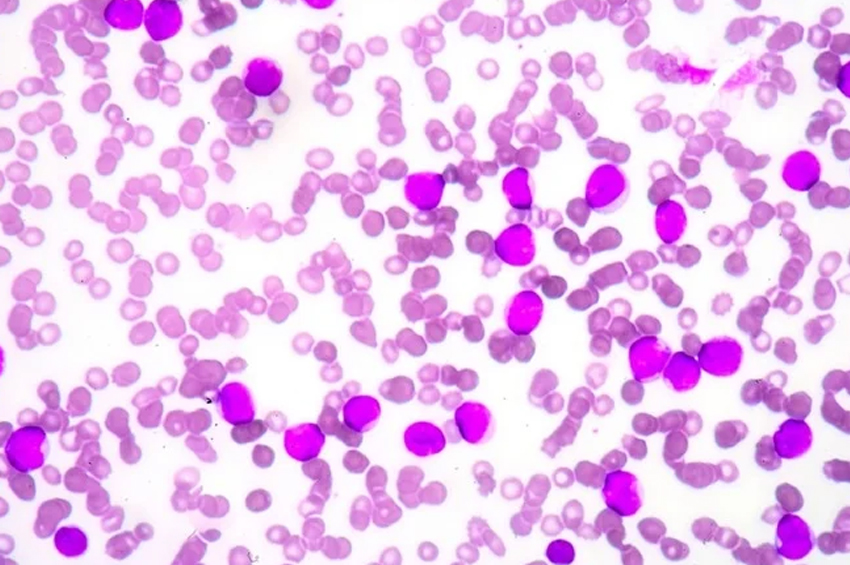

Aplastik Anemi Nedir? Nedenleri, Belirtileri, Tedavisi
Aplastik anemiye ne sebep olur? Aplastik anemi akut veya kronik olabilir ve her yaşta görülebilir. Bununla birlikte, gençlerde daha yaygın olma eğilimindedir. Lösemi ve diğer kan hastalıkları riskini artıran aplastik anemi, tedavi edilmezse aritmi ve kalp yetmezliği gibi ciddi sonuçlara yol açabilir.
Haber Merkezi / Aplastik anemi, kemik iliği hasar gördüğünde gelişir; yeterince kök hücre sentezlenemez. Kök hücreler, diğer kan hücrelerini oluşturan hücrelerdir.
Nedenleri
Aplastik anemi vakalarının çoğu için neden bilinmemektedir. Bununla birlikte, bazı hastalarda nedensel faktörler olarak tanımlanan çeşitli durumlar bulunmaktadır.
Vücudun bağışıklık sisteminin kendi doku ve organlarına saldırdığı bir otoimmün reaksiyon, kemik iliği hasarına neden olabilir. Bağışıklık sisteminin T hücreleri , hematopoietik kök hücrelere saldırır ve onları yok eder; bu, kan hücresi üretimini ve sonraki hücre bölünmesi sürecini bastırır.
İlaçlar ve bazı çevresel toksinler aplastik anemiyi tetikleyebilecek diğer faktörler arasındadır. Kemoterapi ve radyasyon, kanser tedavisi sırasında kanser hücrelerini yok etmek için yaygın olarak kullanılır; ancak kemik iliğindeki kan hücreleri gibi sağlıklı hücrelere de zarar görebilir.
Bazı artrit ilaçları ve antibiyotikler de aplastik anemiye neden olabilir, ancak bu tür ilaçlarla risk çok düşüktür. Pestisitlere, böcek ilaçlarına ve bazı virüslere maruz kalma da aplastik anemi ile ilişkilendirilmiştir. Aplastik anemi hamilelikle de ilişkilendirilebilir; bununla birlikte, aplastik aneminin bu formu kendi kendini sınırlar ve doğumla sona erer.
Kalıtsal aplastik anemi formlarına genetik faktörler neden olur ve yaşamın ilk on yılında görülür. Fanconi anemisi, aplastik aneminin kalıtsal formlarını belirtmek için kullanılan terimdir.
Belirtileri
Aplastik aneminin karakteristik semptomları arasında anemi (kırmızı kan hücrelerinin eksikliği), enfeksiyonlar (beyaz kan hücrelerinin eksikliği) ve kontrolsüz kanama veya morarma (trombosit eksikliği) bulunur. Bazı durumlarda, etkilenen kişi asemptomatiktir ve durum rutin bir kan testi sırasında tespit edilir.
Aplastik anemi, azalmış kırmızı kan hücreleri nedeniyle etkilenen kişiyi anemik hale getirir. Aplastik anemi de kontrolsüz kanamalara yol açar ve kişiyi enfeksiyonlara oldukça yatkın hale getirir. Kontrolsüz kanama, düşük trombositlerden kaynaklanırken, enfeksiyonlara karşı artan duyarlılık, düşük beyaz kan hücrelerinden kaynaklanır.
Aplastik anemide yorgunluk, baş dönmesi, nefes darlığı, düzensiz kalp hızı, soluk cilt, deri döküntüsü ve baş ağrısı görülür.
Teşhisi
Aplastik anemiyi tespit etmek için kan ve laboratuvar testleri kullanılır. Tanıları doğrulamak için kemik iliği aspirasyonu ve biyopsisi de yapılabilir.
Tedavisi
Aplastik aneminin tedavisi, altta yatan nedenin ortadan kaldırılmasını içerir. Aplastik anemi, bağışıklık sistemini baskılayan ilaçlar, kan nakli veya kemik iliği nakli ile tedavi edilebilir.
Dikkat: Sayfa içeriği sadece bilgilendirme amaçlıdır.






























